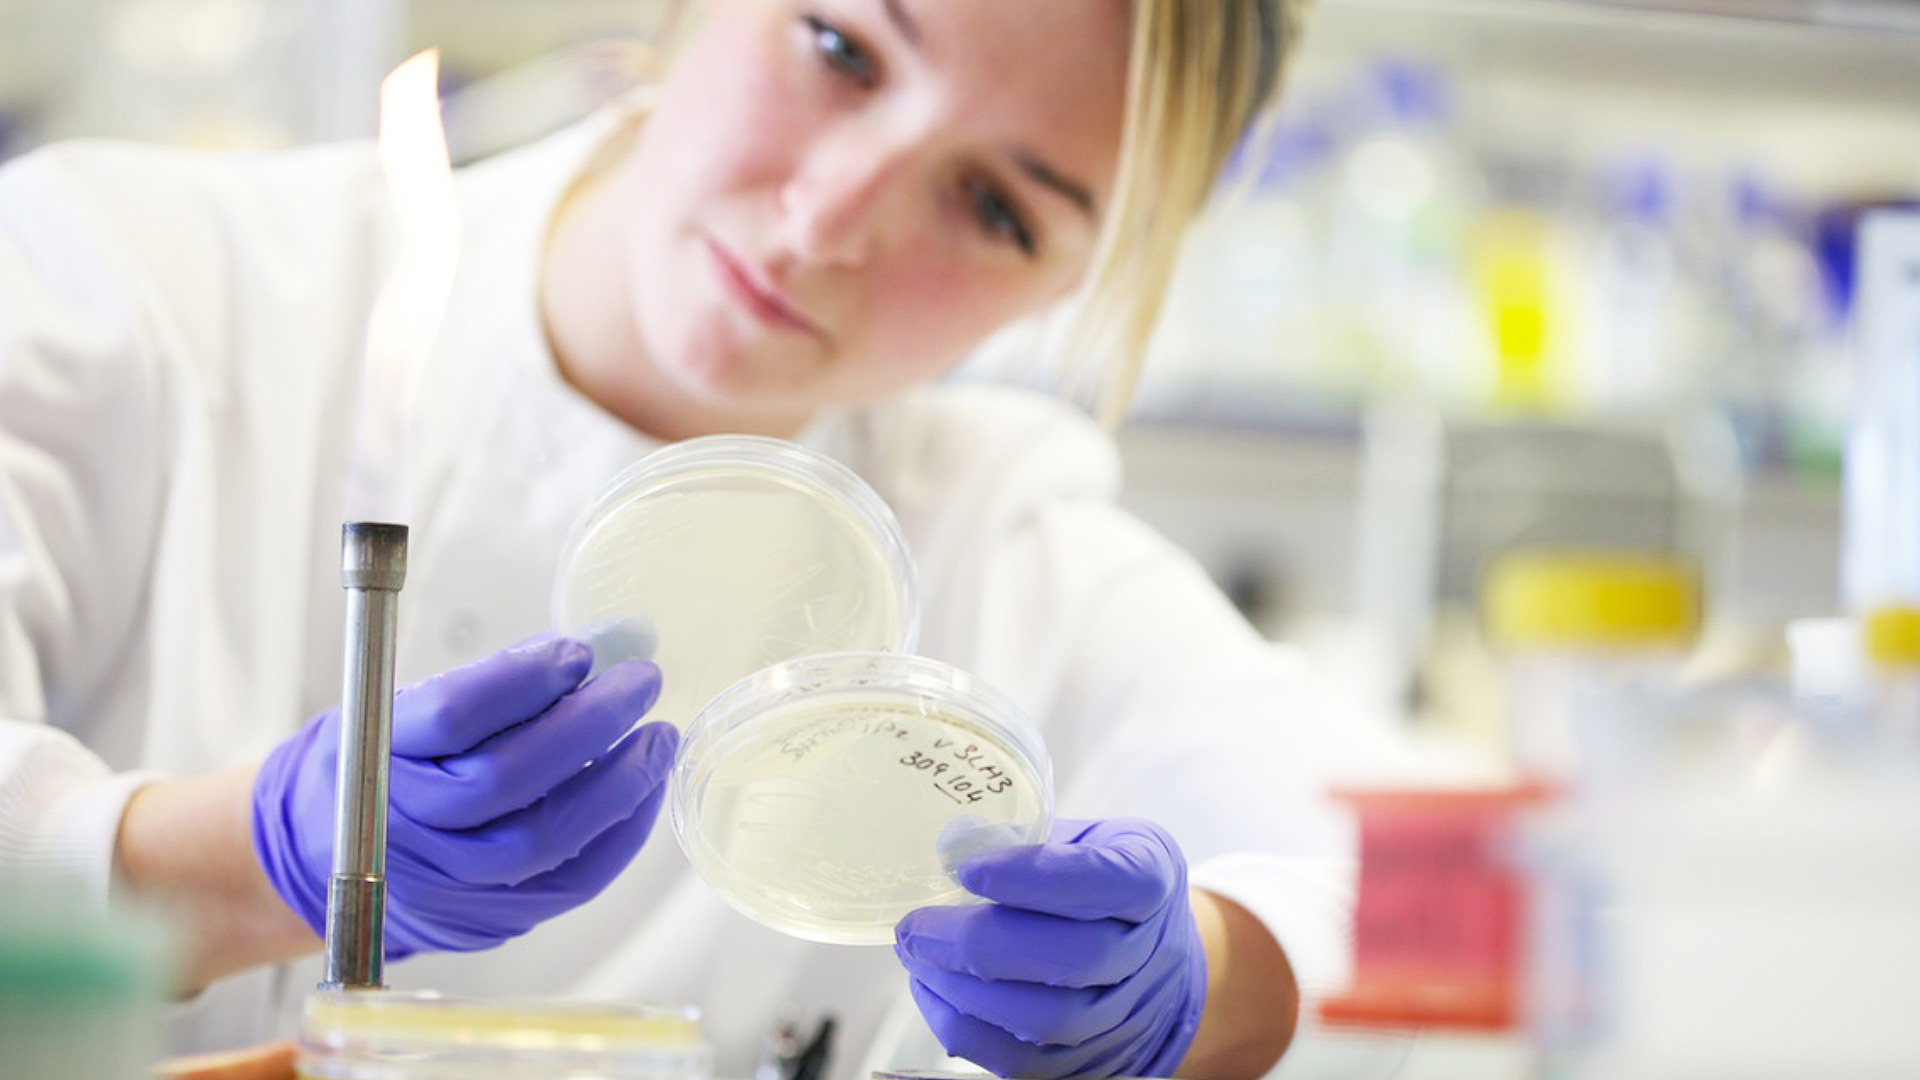
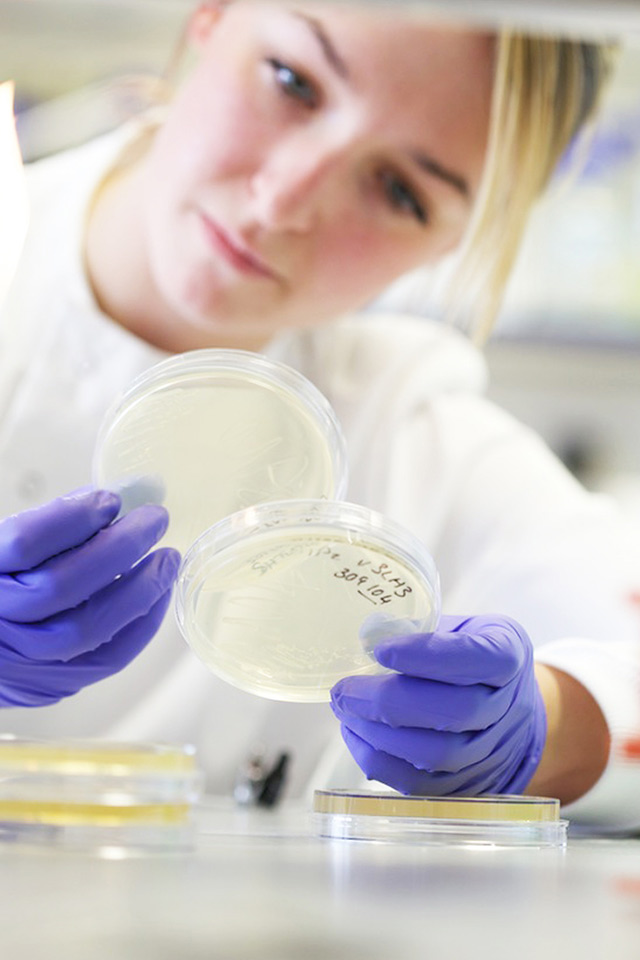

Making a clean sweep
Scroll for more- Client
- Worldwide Cancer Research
- Year
- 2020
Worldwide Cancer Research funds bold research to find cures for cancer. For over 30 years the "Sweeps" regular mailing programme has been a cornerstone of their fundraising. The programme has historically been very successful. This success was built year-on-year through a robust test, learn and roll-out approach to campaign activity. Our challenge was to make the programme even better, so there was more money for the charity to fund more ground-breaking research.
Our starting point was the data. We trawled through their historic activity and results with a strategy of growing revenue through a series of marginal gains. We refined the creative and the targeting to reduce costs and boost engagement and donations. We discovered that small changes wouldn’t deliver the bold change needed, so we changed our perspective to measure the performance of the programme at an individual supporter level. By looking through the lens of how each supporter donated over the longer term, we found patterns and trends in the way people donated.
We back-tested our new approach as a proof of concept, to see how well it could have worked over 6 previous campaigns to ensure the results were robust. Our conclusion was that using the new individual supporter strategy to select customers for a campaign could outperform a more traditional ‘RFM’ selection approach.
Laura McLachlan, Director of Marketing and Fundraising, Worldwide Cancer Research

